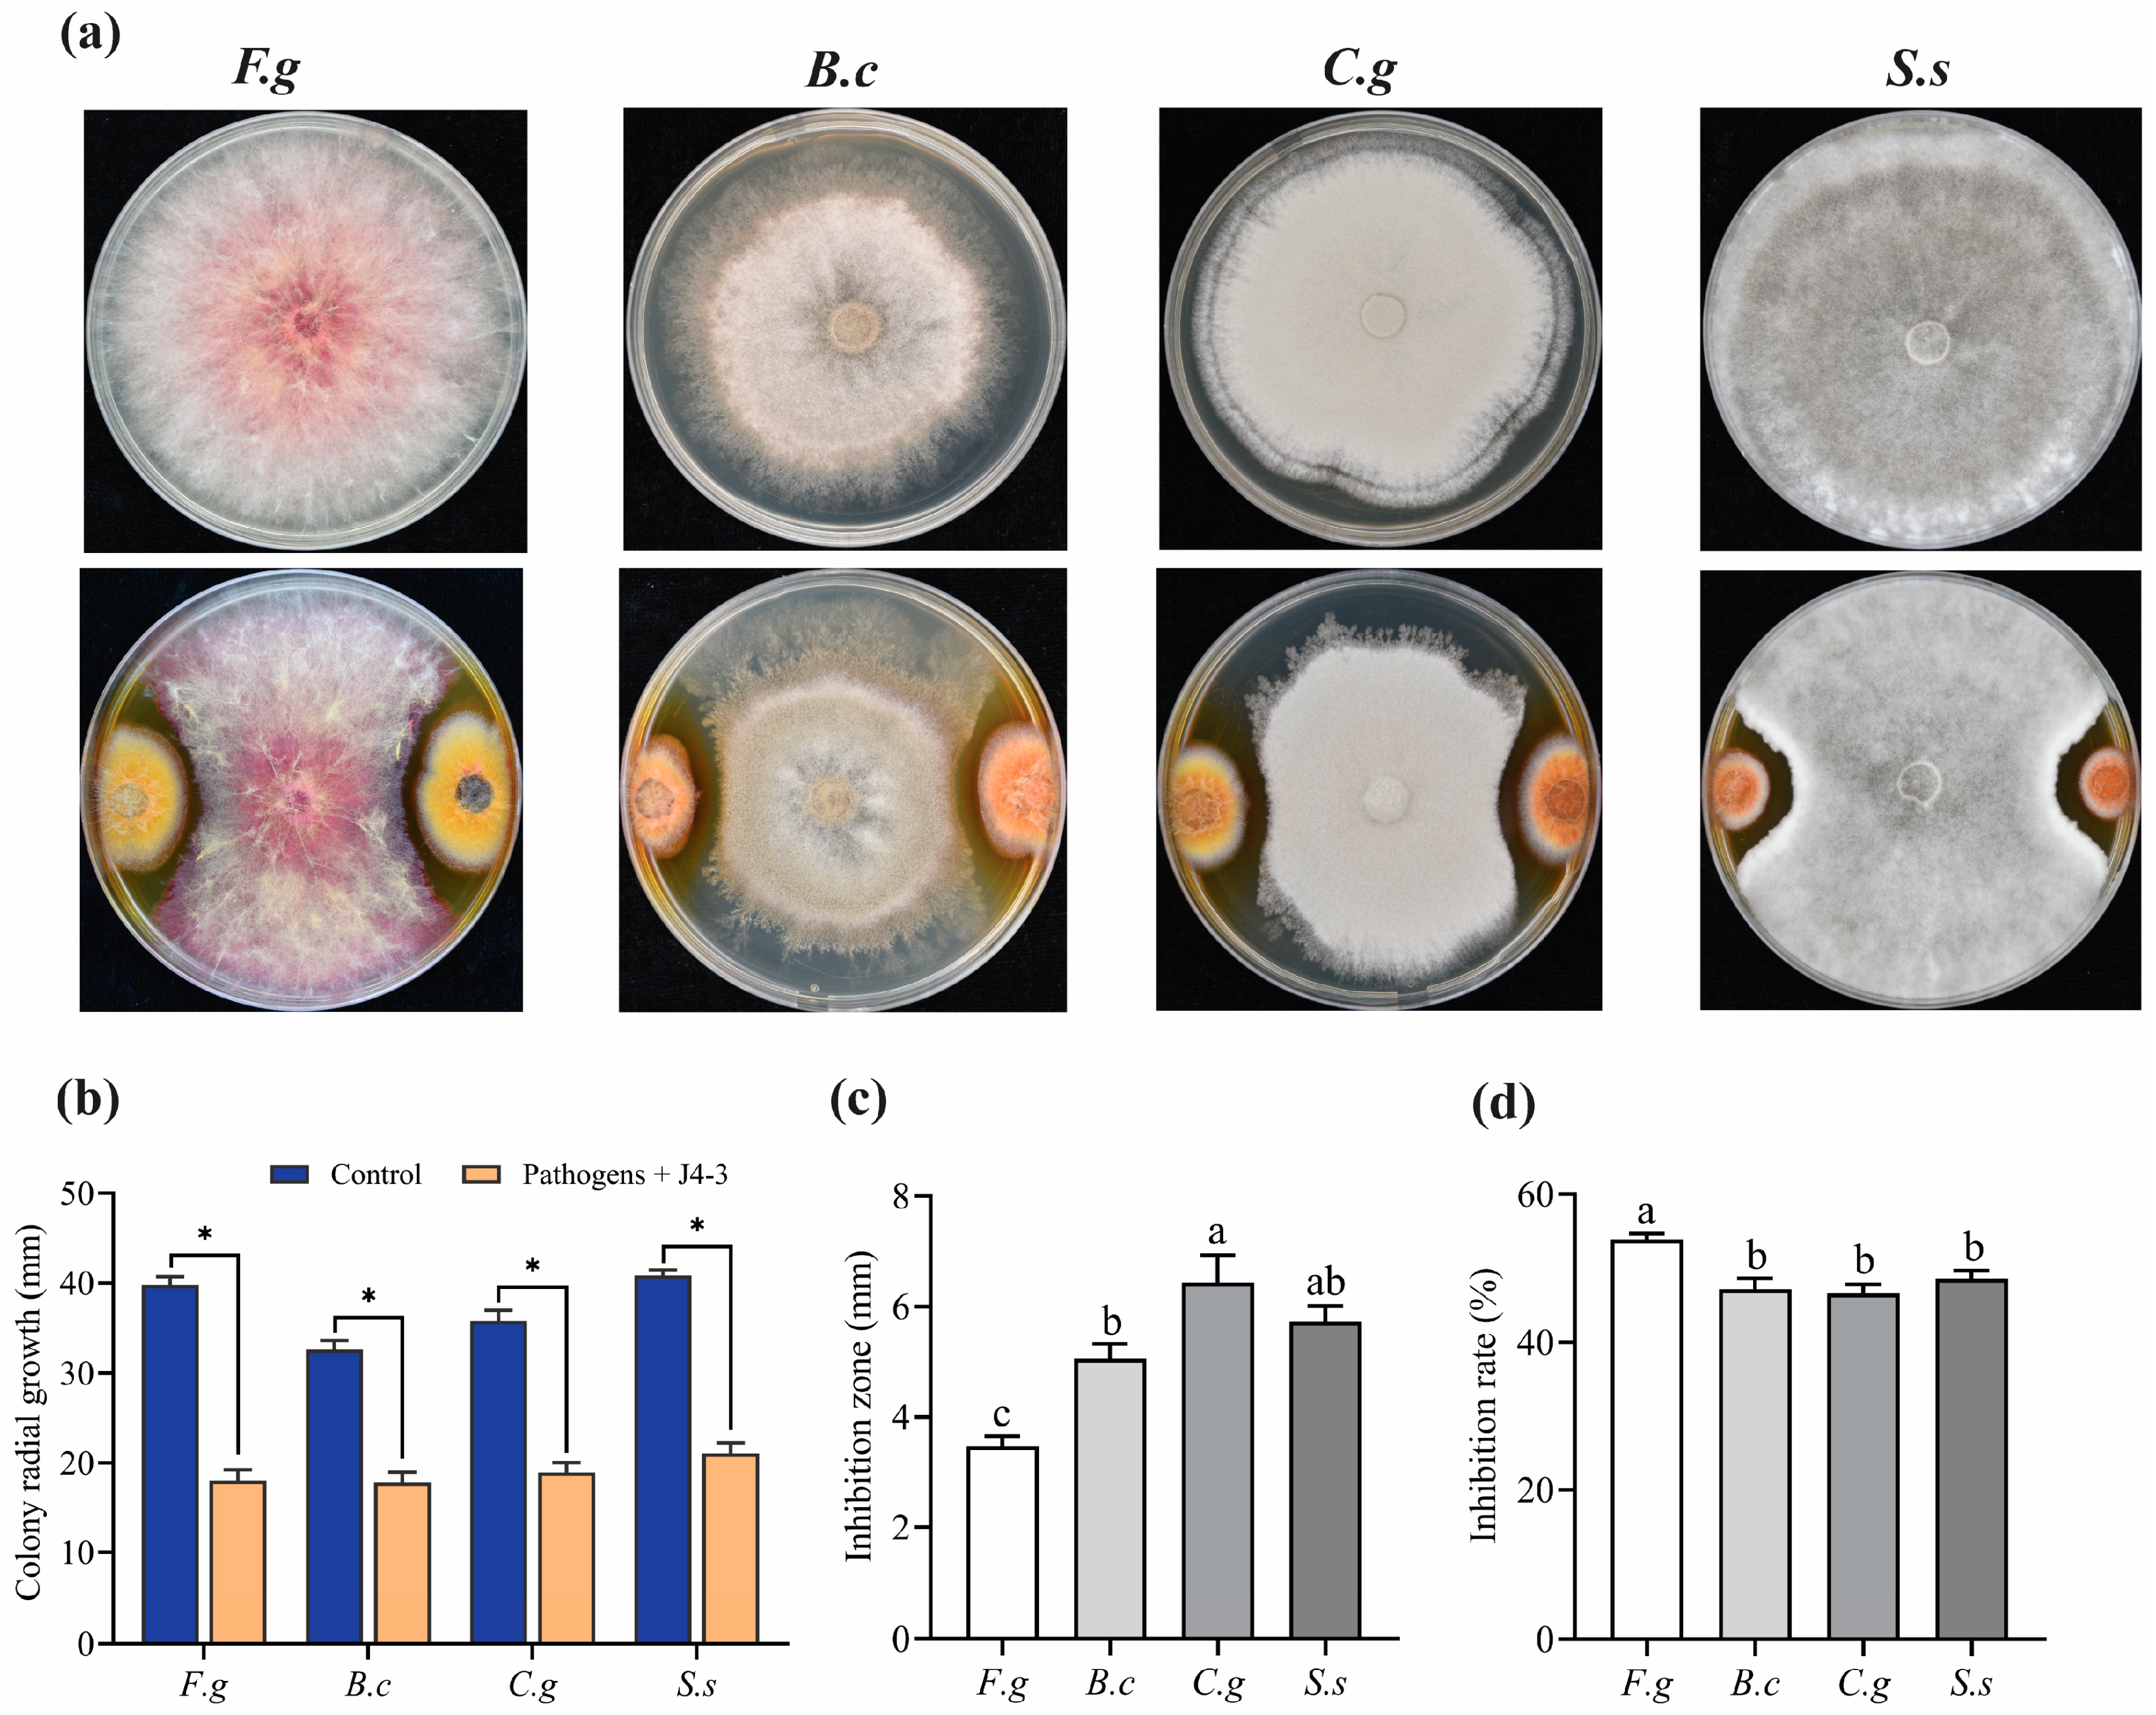
Jof 10 00010 g003

The Wheat Endophyte Epicoccum layuense J4-3 Inhibits Fusarium graminearum and Enhances Plant Growth
Abstract
:1. Introduction
2. Materials and Methods
2.1. Pathogenic Fungal Strains and Culture Conditions
2.2. Endophyte Isolation and Morphological Characterization
2.3. DNA Extraction, PCR Amplification, Sequencing, and Phylogenetic Analysis
2.4. In Vitro Dual Culture Activity of Strain J4-3
2.5. Effect of Hyphal Fragment Suspensions of J4-3 against F. graminearum by Wheat Coleoptile Assay
2.6. Biocontrol Activity of Spore Suspensions and Culture Filtrates of J4-3 against FHB in Field Conditions
2.7. Evaluating the Growth of Wheat Treated with Hyphal Fragment Suspensions of J4-3 in a Greenhouse
2.8. Evaluating the Growth of Wheat Treated with Spore Suspensions of J4-3 under Field Conditions
2.9. Statistical Analysis
3. Results
3.1. Morphological Identification of E. layuense Strain J4-3
3.2. Phylogenetic Analysis
3.3. E. layuense Exhibits Broad-Spectrum Antifungal Activity
3.4. E. layuense Reduces F. graminearum Infection by Wheat Coleoptile Assay
3.5. E. layuense Alleviates the Severity of FHB under Field Conditions
3.6. E. layuense Strain J4-3 Promotes Wheat Growth under Greenhouse and Field Conditions
4. Discussion
Supplementary Materials
Author Contributions
Funding
Institutional Review Board Statement
Informed Consent Statement
Data Availability Statement
Conflicts of Interest
References
- Abaya, A.; Xue, A.; Hsiang, T. Selection and screening of fungal endophytes against wheat pathogens. Biol. Control 2021, 154, 104511. [Google Scholar] [CrossRef]
- Shewry, P.R. Wheat. J. Exp. Bot. 2009, 60, 1537–1553. [Google Scholar] [CrossRef] [PubMed]
- Li, B.; Yuan, B.; Duan, J.; Qin, Y.; Shen, H.; Ren, J.; Francis, F.; Chen, M.; Li, G. Identification of Fcl-29 as an Effective Antifungal Natural Product against Fusarium graminearum and Combinatorial Engineering Strategy for Improving Its Yield. J. Agric. Food Chem. 2023, 71, 5554–5564. [Google Scholar] [CrossRef] [PubMed]
- Kheiri, A.; Moosawi Jorf, S.A.; Malihipour, A. Infection process and wheat response to Fusarium head blight caused by Fusarium graminearum. Eur. J. Plant Pathol. 2019, 153, 489–502. [Google Scholar] [CrossRef]
- Pasquali, M.; Beyer, M.; Logrieco, A.; Audenaert, K.; Balmas, V.; Basler, R.; Boutigny, A.-L.; Chrpová, J.; Czembor, E.; Gagkaeva, T. A European database of Fusarium graminearum and F. culmorum trichothecene genotypes. Front. Microbiol. 2016, 7, 406. [Google Scholar] [CrossRef] [PubMed]
- Vogelgsang, S.; Beyer, M.; Pasquali, M.; Jenny, E.; Musa, T.; Bucheli, T.D.; Wettstein, F.E.; Forrer, H.-R. An eight-year survey of wheat shows distinctive effects of cropping factors on different Fusarium species and associated mycotoxins. Eur. J. Agron. 2019, 105, 62–77. [Google Scholar] [CrossRef]
- Wang, Q.; Vera Buxa, S.; Furch, A.; Friedt, W.; Gottwald, S. Insights into Triticum aestivum seedling root rot caused by Fusarium graminearum. Mol. Plant-Microbe Interact. 2015, 28, 1288–1303. [Google Scholar] [CrossRef]
- Colombo, E.M.; Pizzatti, C.; Kunova, A.; Gardana, C.; Saracchi, M.; Cortesi, P.; Pasquali, M. Evaluation of in-vitro methods to select effective streptomycetes against toxigenic fusaria. PeerJ 2019, 7, e6905. [Google Scholar] [CrossRef]
- Drakopoulos, D.; Meca, G.; Torrijos, R.; Marty, A.; Kägi, A.; Jenny, E.; Forrer, H.-R.; Six, J.; Vogelgsang, S. Control of Fusarium graminearum in wheat with mustard-based botanicals: From in vitro to in planta. Front. Microbiol. 2020, 11, 1595. [Google Scholar] [CrossRef]
- Hu, L.; Guo, C.; Chen, J.; Jia, R.; Sun, Y.; Cao, S.; Xiang, P.; Wang, Y. Venturicidin A Is a Potential Fungicide for Controlling Fusarium Head Blight by Affecting Deoxynivalenol Biosynthesis, Toxisome Formation, and Mitochondrial Structure. J. Agric. Food Chem. 2023, 71, 12440–12451. [Google Scholar] [CrossRef]
- Wang, L.-S.; Zhang, Y.; Zhang, M.-Q.; Gong, D.-C.; Mei, Y.-Z.; Dai, C.-C. Engineered Phomopsis liquidambaris with Fhb1 and Fhb7 Enhances Resistance to Fusarium graminearum in Wheat. J. Agric. Food Chem. 2023, 71, 1391–1404. [Google Scholar] [CrossRef] [PubMed]
- Xu, W.; Zhang, L.; Goodwin, P.H.; Xia, M.; Zhang, J.; Wang, Q.; Liang, J.; Sun, R.; Wu, C.; Yang, L. Isolation, Identification, and Complete Genome Assembly of an endophytic Bacillus velezensis YB-130, potential biocontrol agent against Fusarium graminearum. Front. Microbiol. 2020, 11, 598285. [Google Scholar] [CrossRef] [PubMed]
- Zhu, Y.-L.; Zhang, M.-Q.; Wang, L.-S.; Mei, Y.-Z.; Dai, C.-C. Overexpression of chitinase in the endophyte Phomopsis liquidambaris enhances wheat resistance to Fusarium graminearum. Fungal Genet. Biol. 2022, 158, 103650. [Google Scholar] [CrossRef] [PubMed]
- Chen, Y.; Kistler, H.C.; Ma, Z. Fusarium graminearum trichothecene mycotoxins: Biosynthesis, regulation, and management. Annu. Rev. Phytopathol. 2019, 57, 15–39. [Google Scholar] [CrossRef] [PubMed]
- Chen, J.-H.; Xiang, W.; Cao, K.-X.; Lu, X.; Yao, S.-C.; Hung, D.; Huang, R.-S.; Li, L.-B. Characterization of volatile organic compounds emitted from endophytic Burkholderia cenocepacia ETR-B22 by SPME-GC-MS and their inhibitory activity against various plant fungal pathogens. Molecules 2020, 25, 3765. [Google Scholar] [CrossRef] [PubMed]
- Rani, L.; Thapa, K.; Kanojia, N.; Sharma, N.; Singh, S.; Grewal, A.S.; Srivastav, A.L.; Kaushal, J. An extensive review on the consequences of chemical pesticides on human health and environment. J. Clean. Prod. 2021, 283, 124657. [Google Scholar] [CrossRef]
- Zhang, Y.; Li, T.; Liu, Y.; Li, X.; Zhang, C.; Feng, Z.; Peng, X.; Li, Z.; Qin, S.; Xing, K. Volatile organic compounds produced by Pseudomonas chlororaphis subsp. aureofaciens SPS-41 as biological fumigants to control Ceratocystis fimbriata in postharvest sweet potatoes. J. Agric. Food Chem. 2019, 67, 3702–3710. [Google Scholar] [CrossRef]
- Alijani, Z.; Amini, J.; Ashengroph, M.; Bahramnejad, B. Antifungal activity of volatile compounds produced by Staphylococcus sciuri strain MarR44 and its potential for the biocontrol of Colletotrichum nymphaeae, causal agent strawberry anthracnose. Int. J. Food Microbiol. 2019, 307, 108276. [Google Scholar] [CrossRef]
- Zhizhou, X.; Wang, M.; Du, J.; Huang, T.; Liu, J.; Dong, T. Isolation Burkholderia sp. HQB-1, a promising biocontrol bacteria to protect banana against Fusarium wilt through phenazine-1-carboxylic acid secretion. Front. Microbiol. 2020, 11, 3156. [Google Scholar] [CrossRef]
- Koné, Y.; Alves, E.; Silveira, P.R.; Ferreira, A.N.; De Medeiros, F.H.V.; Cruz-Magalhães, V. Control of blast disease caused by Pyricularia oryzae with Epicoccum nigrum and microscopic studies of their interaction with rice plants under greenhouse conditions. Biol. Control 2022, 167, 104840. [Google Scholar] [CrossRef]
- Lu, Z.; Chen, M.; Long, X.; Yang, H.; Zhu, D. Biological potential of Bacillus subtilis BS45 to inhibit the growth of Fusarium graminearum through oxidative damage and perturbing related protein synthesis. Front. Microbiol. 2023, 14, 1064838. [Google Scholar] [CrossRef] [PubMed]
- Ma, J.-T.; Dong, X.-Y.; Li, Z.-H.; Yan, H.; He, J.; Liu, J.-K.; Feng, T. Antibacterial Metabolites from Kiwi Endophytic Fungus Fusarium tricinctum, a Potential Biocontrol Strain for Kiwi Canker Disease. J. Agric. Food Chem. 2023, 71, 7679–7688. [Google Scholar] [CrossRef] [PubMed]
- Hassani, M.A.; Oppong-Danquah, E.; Feurtey, A.; Tasdemir, D.; Stukenbrock, E.H. Differential regulation and production of secondary metabolites among isolates of the fungal wheat pathogen Zymoseptoria tritici. Appl. Environ. Microbiol. 2022, 88, e02296-21. [Google Scholar] [CrossRef] [PubMed]
- Morsy, M.; Cleckler, B.; Armuelles-Millican, H. Fungal endophytes promote tomato growth and enhance drought and salt tolerance. Plants 2020, 9, 877. [Google Scholar] [CrossRef] [PubMed]
- Mousa, W.K.; Shearer, C.; Limay-Rios, V.; Ettinger, C.L.; Eisen, J.A.; Raizada, M.N. Root-hair endophyte stacking in finger millet creates a physicochemical barrier to trap the fungal pathogen Fusarium graminearum. Nat. Microbiol. 2016, 1, 16167. [Google Scholar] [CrossRef] [PubMed]
- Wang, G.; Ran, H.; Fan, J.; Keller, N.P.; Liu, Z.; Wu, F.; Yin, W.-B. Fungal-fungal cocultivation leads to widespread secondary metabolite alteration requiring the partial loss-of-function VeA1 protein. Sci. Adv. 2022, 8, eabo6094. [Google Scholar] [CrossRef] [PubMed]
- Akutse, K.S.; Maniania, N.; Fiaboe, K.; Van den Berg, J.; Ekesi, S. Endophytic colonization of Vicia faba and Phaseolus vulgaris (Fabaceae) by fungal pathogens and their effects on the life-history parameters of Liriomyza huidobrensis (Diptera: Agromyzidae). Fungal Ecol. 2013, 6, 293–301. [Google Scholar] [CrossRef]
- Gurulingappa, P.; Sword, G.A.; Murdoch, G.; McGee, P.A. Colonization of crop plants by fungal entomopathogens and their effects on two insect pests when in planta. Biol. Control 2010, 55, 34–41. [Google Scholar] [CrossRef]
- Vega, F.E. Insect pathology and fungal endophytes. J. Invertebr. Pathol. 2008, 98, 277–279. [Google Scholar] [CrossRef]
- Jaber, L.R.; Ownley, B.H. Can we use entomopathogenic fungi as endophytes for dual biological control of insect pests and plant pathogens? Biol. Control 2018, 116, 36–45. [Google Scholar] [CrossRef]
- Ownley, B.H.; Griffin, M.R.; Klingeman, W.E.; Gwinn, K.D.; Moulton, J.K.; Pereira, R.M. Beauveria bassiana: Endophytic colonization and plant disease control. J. Invertebr. Pathol. 2008, 98, 267–270. [Google Scholar] [CrossRef] [PubMed]
- Ownley, B.H.; Gwinn, K.D.; Vega, F.E. Endophytic fungal entomopathogens with activity against plant pathogens: Ecology and evolution. BioControl 2010, 55, 113–128. [Google Scholar] [CrossRef]
- Jaber, L.R.; Enkerli, J. Effect of seed treatment duration on growth and colonization of Vicia faba by endophytic Beauveria bassiana and Metarhizium brunneum. Biol. Control 2016, 103, 187–195. [Google Scholar] [CrossRef]
- Jaber, L.R.; Enkerli, J. Fungal entomopathogens as endophytes: Can they promote plant growth? Biocontrol Sci. Technol. 2017, 27, 28–41. [Google Scholar] [CrossRef]
- Lopez, D.C.; Sword, G.A. The endophytic fungal entomopathogens Beauveria bassiana and Purpureocillium lilacinum enhance the growth of cultivated cotton (Gossypium hirsutum) and negatively affect survival of the cotton bollworm (Helicoverpa zea). Biol. Control 2015, 89, 53–60. [Google Scholar] [CrossRef]
- Elena, G.J.; Beatriz, P.J.; Alejandro, P.; Lecuona, R. Metarhizium anisopliae (Metschnikoff) Sorokin promotes growth and has endophytic activity in tomato plants. Adv. Biol. Res. 2011, 5, 22–27. [Google Scholar]
- Jaber, L.R. Seed inoculation with endophytic fungal entomopathogens promotes plant growth and reduces crown and root rot (CRR) caused by Fusarium culmorum in wheat. Planta 2018, 248, 1525–1535. [Google Scholar] [CrossRef]
- Tian, B.; Xie, J.; Fu, Y.; Cheng, J.; Li, B.; Chen, T.; Zhao, Y.; Gao, Z.; Yang, P.; Barbetti, M.J. A cosmopolitan fungal pathogen of dicots adopts an endophytic lifestyle on cereal crops and protects them from major fungal diseases. ISME J. 2020, 14, 3120–3135. [Google Scholar] [CrossRef]
- Del Frari, G.; Cabral, A.; Nascimento, T.; Boavida Ferreira, R.; Oliveira, H. Epicoccum layuense a potential biological control agent of esca-associated fungi in grapevine. PLoS ONE 2019, 14, e0213273. [Google Scholar] [CrossRef]
- Taguiam, J.D.; Evallo, E.; Balendres, M.A. Epicoccum species: Ubiquitous plant pathogens and effective biological control agents. Eur. J. Plant Pathol. 2021, 159, 713–725. [Google Scholar] [CrossRef]
- Alcock, A.; Elmer, P.; Marsden, R.; Parry, F. Inhibition of Botrytis cinerea by Epirodin: A secondary metabolite from New Zealand isolates of Epicoccum nigrum. J. Phytopathol. 2015, 163, 841–852. [Google Scholar] [CrossRef]
- El Amrani, M.; Lai, D.; Debbab, A.; Aly, A.H.; Siems, K.; Seidel, C.; Schnekenburger, M.; Gaigneaux, A.; Diederich, M.; Feger, D. Protein kinase and HDAC inhibitors from the endophytic fungus Epicoccum nigrum. J. Nat. Prod. 2014, 77, 49–56. [Google Scholar] [CrossRef] [PubMed]
- Cao, S.; Liang, Q.; Nzabanita, C.; Li, Y. Paraphoma root rot of alfalfa (Medicago sativa) in Inner Mongolia, China. Plant Pathol. 2020, 69, 231–239. [Google Scholar] [CrossRef]
- Xu, S.; Christensen, M.J.; Li, Y. Pathogenicity and characterization of Colletotrichum lentis: A causal agent of anthracnose in common vetch (Vicia sativa). Eur. J. Plant Pathol. 2017, 149, 719–731. [Google Scholar] [CrossRef]
- Yin, C.; Wang, Y.; Zhang, Y.; Wang, H.; Tao, R.; Li, Y.; Sung, C.K. A pine wood sample preparation method for high target and quality DNA extraction for detection of Esteya vermicola by PCR from living pine. J. Basic Microbiol. 2019, 59, 437–441. [Google Scholar] [CrossRef] [PubMed]
- White, T.J.; Bruns, T.; Lee, S.; Taylor, J. Amplification and direct sequencing of fungal ribosomal RNA genes for phylogenetics. PCR Protoc. Guide Methods Appl. 1990, 18, 315–322. [Google Scholar]
- Chen, Q.; Hou, L.; Duan, W.; Crous, P.; Cai, L. Didymellaceae revisited. Stud. Mycol. 2017, 87, 105–159. [Google Scholar] [CrossRef]
- Nzabanita, C.; Zhang, L.; Zhao, H.; Wang, Y.; Wang, Y.; Sun, M.; Wang, S.; Guo, L. Fungal endophyte Epicoccum nigrum 38L1 inhibits in vitro and in vivo the pathogenic fungus Fusarium graminearum. Biol. Control 2022, 174, 105010. [Google Scholar] [CrossRef]
- Yu, X.; Li, B.; Fu, Y.; Xie, J.; Cheng, J.; Ghabrial, S.A.; Li, G.; Yi, X.; Jiang, D. Extracellular transmission of a DNA mycovirus and its use as a natural fungicide. Proc. Natl. Acad. Sci. USA 2013, 110, 1452–1457. [Google Scholar] [CrossRef]
- Li, P.; Lin, Y.; Zhang, H.; Wang, S.; Qiu, D.; Guo, L. Molecular characterization of a novel mycovirus of the family Tymoviridae isolated from the plant pathogenic fungus Fusarium graminearum. Virology 2016, 489, 86–94. [Google Scholar] [CrossRef]
- Han, C.; Yu, Z.; Zhang, Y.; Wang, Z.; Zhao, J.; Huang, S.-X.; Ma, Z.; Wen, Z.; Liu, C.; Xiang, W. Discovery of Frenolicin B as Potential Agrochemical Fungicide for Controlling Fusarium Head Blight on Wheat. J. Agric. Food Chem. 2021, 69, 2108–2117. [Google Scholar] [CrossRef] [PubMed]
- Palazzini, J.M.; Alberione, E.; Torres, A.; Donat, C.; Köhl, J.; Chulze, S. Biological control of Fusarium graminearum sensu stricto, causal agent of Fusarium head blight of wheat, using formulated antagonists under field conditions in Argentina. Biol. Control 2016, 94, 56–61. [Google Scholar] [CrossRef]
- Uwaremwe, C.; Yue, L.; Wang, Y.; Tian, Y.; Zhao, X.; Liu, Y.; Zhou, Q.; Zhang, Y.; Wang, R. An endophytic strain of Bacillus amyloliquefaciens suppresses Fusarium oxysporum infection of chinese wolfberry by altering its rhizosphere bacterial community. Front. Microbiol. 2022, 12, 782523. [Google Scholar] [CrossRef] [PubMed]
- Kusari, S.; Hertweck, C.; Spiteller, M. Chemical ecology of endophytic fungi: Origins of secondary metabolites. Chem. Biol. 2012, 19, 792–798. [Google Scholar] [CrossRef] [PubMed]
- Lata, R.; Chowdhury, S.; Gond, S.K.; White, J.F., Jr. Induction of abiotic stress tolerance in plants by endophytic microbes. Lett. Appl. Microbiol. 2018, 66, 268–276. [Google Scholar] [CrossRef] [PubMed]
- Oldrup, E.; McLain-Romero, J.; Padilla, A.; Moya, A.; Gardner, D.; Creamer, R. Localization of endophytic Undifilum fungi in locoweed seed and influence of environmental parameters on a locoweed in vitro culture system. Botany 2010, 88, 512–521. [Google Scholar] [CrossRef]
- Chen, H.; Li, C.; White, J. First report of Epicoccum layuense causing brown leaf spot on oat (Avena sativa) in northwestern China. Plant Dis. 2020, 104, 990. [Google Scholar] [CrossRef]
- Chen, H.; Xue, L.; White, J.F.; Kamran, M.; Li, C. Identification and characterization of Pyrenophora species causing leaf spot on oat (Avena sativa) in western China. Plant Pathol. 2022, 71, 566–577. [Google Scholar] [CrossRef]
- Imran, Z.K.; Ali Hasan, K.M.; Ali, Z.H. A novel taxonomic study of the Helmintho sporium link ex fries status and closed related genera. Biochem. Cell. Arch. 2018, 18, 927–935. [Google Scholar]
- Bian, J.-Y.; Fang, Y.-L.; Song, Q.; Sun, M.-L.; Yang, J.-Y.; Ju, Y.-W.; Li, D.-W.; Huang, L. The fungal endophyte Epicoccum dendrobii as a potential biocontrol agent against Colletotrichum gloeosporioides. Phytopathology® 2021, 111, 293–303. [Google Scholar] [CrossRef]
- Hamzah, T.N.T.; Lee, S.Y.; Hidayat, A.; Terhem, R.; Faridah-Hanum, I.; Mohamed, R. Diversity and characterization of endophytic fungi isolated from the tropical mangrove species, Rhizophora mucronata, and identification of potential antagonists against the soil-borne fungus, Fusarium solani. Front. Microbiol. 2018, 9, 1707. [Google Scholar] [CrossRef] [PubMed]
- Vinayarani, G.; Prakash, H. Fungal endophytes of turmeric (Curcuma longa L.) and their biocontrol potential against pathogens Pythium aphanidermatum and Rhizoctonia solani. World J. Microbiol. Biotechnol. 2018, 34, 49. [Google Scholar] [CrossRef] [PubMed]
- Hu, J.; Zheng, M.; Dang, S.; Shi, M.; Zhang, J.; Li, Y. Biocontrol potential of Bacillus amyloliquefaciens LYZ69 against anthracnose of alfalfa (Medicago sativa). Phytopathology® 2021, 111, 1338–1348. [Google Scholar] [CrossRef] [PubMed]
- Qiu, H.; Zhao, X.; Fang, W.; Wu, H.; Abubakar, Y.S.; Lu, G.-D.; Wang, Z.; Zheng, W. Spatiotemporal nature of Fusarium graminearum-wheat coleoptile interactions. Phytopathol. Res. 2019, 1, 26. [Google Scholar] [CrossRef]
- Zhang, L.; Wang, S.; Ruan, S.; Nzabanita, C.; Wang, Y.; Guo, L. A Mycovirus VIGS Vector Confers Hypovirulence to a Plant Pathogenic Fungus to Control Wheat FHB. Adv. Sci. 2023, 10, 2302606. [Google Scholar] [CrossRef] [PubMed]
- Kumbar, B.; Mahmood, R.; Nagesha, S.; Nagaraja, M.; Prashant, D.; Kerima, O.Z.; Karosiya, A.; Chavan, M. Field application of Bacillus subtilis isolates for controlling late blight disease of potato caused by Phytophthora infestans. Biocatal. Agric. Biotechnol. 2019, 22, 101366. [Google Scholar] [CrossRef]
- Cui, L.; Yang, C.; Wei, L.; Li, T.; Chen, X. Isolation and identification of an endophytic bacteria Bacillus velezensis 8-4 exhibiting biocontrol activity against potato scab. Biol. Control 2020, 141, 104156. [Google Scholar] [CrossRef]
- Wang, D.; Luo, W.-Z.; Zhang, D.-D.; Li, R.; Kong, Z.-Q.; Song, J.; Dai, X.-F.; Alkan, N.; Chen, J.-Y. Insights into the Biocontrol Function of a Burkholderia gladioli Strain against Botrytis cinerea. Microbiol. Spectr. 2023, 11, e04805-22. [Google Scholar] [CrossRef]
- Li, T.; Im, J.; Lee, J. Genetic Diversity of Epicoccum nigrum and its Effects on Fusarium graminearum. Mycobiology 2022, 50, 457–466. [Google Scholar] [CrossRef]
- Bagy, H.M.K.; Hassan, E.A.; Nafady, N.A.; Dawood, M.F. Efficacy of arbuscular mycorrhizal fungi and endophytic strain Epicoccum nigrum ASU11 as biocontrol agents against blackleg disease of potato caused by bacterial strain Pectobacterium carotovora subsp. atrosepticum PHY7. Biol. Control 2019, 134, 103–113. [Google Scholar] [CrossRef]
- Fávaro, L.C.D.L.; Sebastianes, F.L.D.S.; Araújo, W.L. Epicoccum nigrum P16, a sugarcane endophyte, produces antifungal compounds and induces root growth. PLoS ONE 2012, 7, e36826. [Google Scholar] [CrossRef] [PubMed]
- Koutb, M.; Ali, E.H. Potential of Epicoccum purpurascens strain 5615 AUMC as a biocontrol agent of Pythium irregulare root rot in three leguminous plants. Mycobiology 2010, 38, 286–294. [Google Scholar] [CrossRef]
- Aveskamp, M.M.; Verkley, G.J.; de Gruyter, J.; Murace, M.A.; Perello, A.; Woudenberg, J.H.; Groenewald, J.Z.; Crous, P.W. DNA phylogeny reveals polyphyly of Phoma section Peyronellaea and multiple taxonomic novelties. Mycologia 2009, 101, 363–382. [Google Scholar] [CrossRef]
- De Gruyter, J.; Woudenberg, J.; Aveskamp, M.; Verkley, G.; Groenewald, J.; Crous, P. Redisposition of Phoma-like anamorphs in Pleosporales. Stud. Mycol. 2013, 75, 1–36. [Google Scholar] [CrossRef]

Disclaimer/Publisher’s Note: The statements, opinions and data contained in all publications are solely those of the individual author(s) and contributor(s) and not of MDPI and/or the editor(s). MDPI and/or the editor(s) disclaim responsibility for any injury to people or property resulting from any ideas, methods, instructions or products referred to in the content. |
© 2023 by the authors. Licensee MDPI, Basel, Switzerland. This article is an open access article distributed under the terms and conditions of the Creative Commons Attribution (CC BY) license (https://creativecommons.org/licenses/by/4.0/).
Share and Cite
Nzabanita, C.; Zhang, L.; Wang, Y.; Wang, S.; Guo, L. The Wheat Endophyte Epicoccum layuense J4-3 Inhibits Fusarium graminearum and Enhances Plant Growth. J. Fungi 2024, 10, 10. https://doi.org/10.3390/jof10010010
Nzabanita C, Zhang L, Wang Y, Wang S, Guo L. The Wheat Endophyte Epicoccum layuense J4-3 Inhibits Fusarium graminearum and Enhances Plant Growth. Journal of Fungi. 2024; 10(1):10. https://doi.org/10.3390/jof10010010
Chicago/Turabian StyleNzabanita, Clement, Lihang Zhang, Yanfei Wang, Shuangchao Wang, and Lihua Guo. 2024. "The Wheat Endophyte Epicoccum layuense J4-3 Inhibits Fusarium graminearum and Enhances Plant Growth" Journal of Fungi 10, no. 1: 10. https://doi.org/10.3390/jof10010010
APA StyleNzabanita, C., Zhang, L., Wang, Y., Wang, S., & Guo, L. (2024). The Wheat Endophyte Epicoccum layuense J4-3 Inhibits Fusarium graminearum and Enhances Plant Growth. Journal of Fungi, 10(1), 10. https://doi.org/10.3390/jof10010010

